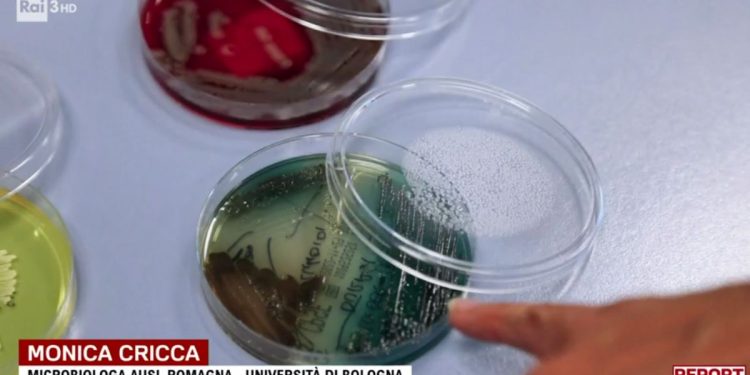
Dei super batteri, colpevoli dell'antibiotico-resistenza (Rai 3, Report)

Antibiotico-resistenza: la pandemia silenziosa
La puntata di ieri di Report, in onda su Rai 3, è tornata a parlare della questione dei super batteri, che stanno portando avanti una silenziosa pandemia quella dell’antibiotico-resistenza, che pone il bel paese al primo posto in Europa per decessi. In Italia, infatti, all’anno muoiono 15 mila persone per via dei super batteri, rispetto ad un totale mondiale che supera 1 milione e 300 mila decessi. In tutto questo, i super batteri aprirebbero anche nuove questioni legate al conteggio per i decessi da covid, che sono stati probabilmente ampiamente sovrastimati, sempre secondo l’inchiesta di Report.
Tornando, però, all’aspetto più preoccupante, ovvero i super batteri e la loro pandemia da antibiotico-resistenza, questi sarebbero in costante crescita, tanto in Italia quanto nel resto del mondo. Nello specifico, si tratta di super batteri, in grado di resistere agli antibiotici che attualmente usiamo, ed in alcuni casi ne sarebbero stati individuati anche di resistenti al 100%, quindi assolutamente incurabili. Normalmente questi circolano negli ospedali, mentre, come spiega Evelina Tacconelli, direttrice malattie infettive dell’azienda ospedaliera integrativa di Verona, con il covid “c’è stata una riduzione dell’attenzione alla trasmissione dei batteri ospedalieri. Il medico era completamente bardato, i pazienti costretti in stanze piccolissime. I virus dell’antibiotico-resistenza sono da contatto, se mi vesto da astronauta e visito un paziente, dovrei poi cambiare la tuta prima del paziente successivo, ma era impensabile”.
Perché nessuno ha fatto nulla per l’antibiotico-resistenza
Insomma, quella che ha tutti i tratti di essere una preoccupante pandemia, l’antibiotico-resistenza, non è stata sufficientemente controllata da chi di competenza. I primi allarmi sono arrivati, secondo Report, nel 2017, quando venne redatto il Pncar (piano nazionale contrasto antimicrobico-resistenza), che prevedeva un investimento da 40 milioni di euro. Il problema è che quei soldi non sono mai arrivati agli ospedali, incastrati al Ministero della Salute per via di un’intesa che venne a mancare tra l’organo di programmazione e quello di progettatine del Ministero della Salute.
I problemi a cui allude la trasmissione Rai in merito al piano contro l’antibiotico-resistenza lo spiega lucidamente Andrea Urbani, direttore generale della Programmazione del Ministero della salute tra il 2017 e i 2022. “Il problema”, spiega, “è che l’intesa fu fatta male, perché non stabiliva né criteri di ricatto, né finalità, né modi di controllo, quindi era inapplicabile“. Non bastava, insomma, secondo lui, stanziare soldi senza un progetto solido a fare da collante. Mancavano i controlli obbligatori in merito alle infezioni da antibiotico-resistenza e non vennero stabiliti dei criteri in merito, così come non furono affidate alle regioni le risorse necessarie per controllare la diffusione di questi super batteri. Ora, però, spiega la trasmissione, il Governo ha stabilito lo stanziamento di altri 40 milioni in questo ambito, sperando che questa volta vengano concretamente stanziati.
Antibiotico-resistenza: “Fino a 10 milioni di morti in futuro”
In merito all’antibiotico-resistenza, inoltre, particolarmente interessante si è dimostrata la proiezione dell’economista inglese Jim O’Neill, commissionata proprio dal governo inglese sui super batteri. “Il numero di persone che muoiono per l’antibiotico-resistenza”, spiega a Report, “è doppio rispetto alle stime del 2016, quindi se fai una proiezione è molto facile che si raggiungeranno anche i 10 milioni di morti. Il covid ha detto al mondo che molte persone possono morire per le infezioni, e questo è positivo, ed ero sorpreso che si iniziasse a parlare di super batteri, ma ora improvvisamente non ci sono soldi. Il mio appello, al governo italiano ma anche a tutto il mondo, è di trattare questo tema con maggiore serietà, o da qui al 2050 quello che è successo con il covid sembrerà una passeggiata in giardino“. Agghiacciante anche la conclusione di Evelina Tacconelli, che sostiene che con questi batteri il rischio è che le chemioterapie diventino inutili, “il tumore sarà debellato, ma il paziente morirà di una di queste infezioni. È la fine della medicina moderna“.